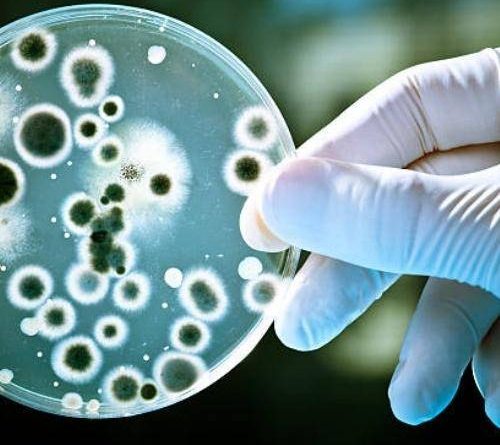

Candida auris: o que é, como se prevenir e quais produtos usar?
Candida auris: como combater e prevenir o superfungo hospitalar que preocupa a saúde mundial?
A Candida auris é um dos maiores desafios da atualidade no controle de infecções hospitalares. Conhecida como superfungo hospitalar, essa espécie resistente vem chamando a atenção de autoridades sanitárias no mundo todo — incluindo a Organização Mundial da Saúde (OMS) e a Anvisa — por sua capacidade de sobreviver em superfícies e resistir a diversos medicamentos e desinfetantes convencionais.
Identificada pela primeira vez em 2009, no Japão, em um paciente com infecção no conduto auditivo, a Candida auris rapidamente se espalhou por mais de 40 países, causando surtos em unidades de terapia intensiva (UTIs) e outros ambientes hospitalares críticos.
No Brasil, o fungo já foi detectado em estados como Bahia, Pernambuco e Minas Gerais, com registros recentes de superfungo Candida auris em Belo Horizonte (BH), reforçando a urgência de medidas preventivas eficazes.
Diferente de outras espécies do gênero Candida, como a Candida albicans, a Candida auris apresenta um comportamento preocupante: é capaz de persistir por dias em superfícies hospitalares, resistir a agentes químicos comuns e causar infecções invasivas graves, especialmente em pacientes imunocomprometidos.
Neste artigo, você vai entender o que é a Candida auris, como ocorre sua transmissão, quais são os sintomas e, principalmente, como prevenir e combater esse superfungo com o uso de desinfetantes hospitalares de alta performance, como a linha Optigerm, com eficácia comprovada contra esse microrganismo.
CONTEÚDO:
- O que é a Candida Auris?
- Como ocorre a transmissão do superfungo Candida auris?
- Candida auris no Brasil: casos recentes e dados atualizados
- Quais os sintomas da Candida auris?
- Por que o superfungo Candida auris preocupa tanto?
- Como previnir e combater a Candida auris em ambientes hospitalares?
- Quais produtos combatem a Candida auris?
- FAQ – Perguntas Frequentes sobre Candida auris
- Higiclear: sua parceira na promoção da saúde em ambientes hospitalares.
O que é a Candida Auris?
A Candida auris, também conhecida como fungo Candida auris ou simplesmente C. auris, é uma espécie emergente de fungo que se tornou motivo de preocupação mundial pela sua alta resistência a medicamentos antifúngicos e pela dificuldade de eliminação no ambiente hospitalar.
Seu nome vem do latim auris, que significa “orelha”, pois foi identificada pela primeira vez em 2009, no Japão, em um paciente com uma infecção no canal auditivo. Desde então, esse microrganismo se espalhou para dezenas de países, provocando surtos hospitalares de difícil controle.
A Candida auris pertence ao mesmo gênero de fungos que inclui espécies comuns da flora humana, como a Candida albicans. No entanto, o que a torna diferente — e mais perigosa — é a sua capacidade de sobreviver em superfícies inanimadas por longos períodos, resistindo ao calor, à umidade e a muitos desinfetantes de uso comum. Isso significa que ela pode permanecer em camas, maçanetas, ventiladores e equipamentos médicos, mesmo após procedimentos de limpeza inadequados.
+LEIA TAMBÉM: Você Sabe Como se Proteger da Contaminação Cruzada?
Além disso, o superfungo Candida auris é capaz de formar biofilmes, uma espécie de camada protetora que aumenta ainda mais sua resistência. Essa característica faz com que sua presença represente um risco elevado para pacientes internados, especialmente em UTIs e centros cirúrgicos, onde há maior vulnerabilidade e contato com dispositivos invasivos.
Estudos apontam que o fungo pode causar infecções na corrente sanguínea, feridas, trato urinário e até colonizar a pele de pacientes. Em muitos casos, o diagnóstico é demorado ou incorreto, já que a Candida auris pode ser confundida com outras espécies de Candida em exames laboratoriais convencionais.

Como ocorre a transmissão do superfungo Candida auris?
A Candida auris é considerada um superfungo hospitalar devido à sua capacidade de se espalhar rapidamente em ambientes de saúde e de sobreviver por longos períodos em diferentes tipos de superfícies.
Diferente de outros fungos do gênero Candida, o superfungo Candida auris não depende apenas de hospedeiros humanos — ele consegue persistir em equipamentos médicos, paredes, roupas de cama e até na pele de profissionais e pacientes.
A transmissão do fungo Candida auris ocorre, principalmente, por contato direto ou indireto:
- Contato direto: quando uma pessoa saudável entra em contato com um paciente infectado ou colonizado, especialmente por meio das mãos ou pele contaminada.
- Contato indireto: quando há exposição a superfícies, instrumentos ou objetos contaminados, como respiradores, termômetros e bombas de infusão.
Essa resistência ambiental faz com que o super fungo Candida auris se torne um dos microrganismos mais difíceis de controlar dentro dos hospitais. Ele é classificado como uma infecção relacionada à assistência à saúde (IRAS) e tem sido responsável por surtos hospitalares graves em várias regiões do Brasil, incluindo casos confirmados do superfungo Candida auris em BH (Belo Horizonte), conforme alertas recentes da Anvisa e do Ministério da Saúde.
Além da alta resistência, a Candida auris apresenta uma característica particularmente preocupante: pode colonizar a pele sem causar sintomas imediatos, permanecendo por semanas no corpo de um indivíduo.
Essa colonização silenciosa facilita a disseminação do fungo Candida auris na pele e sua transferência para outros pacientes ou superfícies hospitalares, mesmo antes da infecção ser diagnosticada.
+LEIA MAIS: O que é Infecção Hospitalar ou IRAS, quais as suas causas e como funcionam?
Por esses motivos, a limpeza e desinfecção profissional são consideradas as principais medidas de contenção. Produtos convencionais, como álcool 70%, muitas vezes não são suficientes para eliminar o auris candida, o que reforça a importância de usar desinfetantes hospitalares com laudos comprovados de eficácia contra a Candida auris.


Candida auris no Brasil: casos recentes e dados atualizados
A presença do superfungo Candida auris no Brasil não é algo distante — já foram registrados vários surtos e casos ao longo dos últimos anos, com destaque para estados como Bahia, Pernambuco, Minas Gerais e São Paulo. A seguir, você confere um panorama atualizado:
Linha do tempo e estatísticas oficiais
- De acordo com a Anvisa, até 10 de abril de 2025 foram notificados 19 surtos e 115 casos de Candida auris no país.
- Entre esses, 85 % eram casos de colonização e 15 % de infecção propriamente dita.
- Importante: a Anvisa adota a definição de surto desde 1 único caso notificado em serviços de saúde.
Casos por estados e eventos recentes:
| Estado / Local | Ano / Período | Nº de casos / surto | Situação / notas |
|---|---|---|---|
| Bahia (Salvador) | 2020 | 15 casos (1º surto no país) | Encerrado Surtos contidos após medidas de controle. |
| Pernambuco (Recife) | 2022 | 47 casos no maior surto + eventos menores | Encerrado Rotinas de vigilância e desinfecção aprimoradas. |
| Minas Gerais (Belo Horizonte) | 2024 | 4 casos (Hospital João XXIII) | Vigilância ativa Conhecido como “superfungo Candida auris BH”. |
| São Paulo (capital – HSPE) | Início de 2025 | 15 casos (1 infecção + 14 colonizações) | Em monitoramento Isolamento e limpeza reforçados. |
| Outros registros (SP, RJ) | 2023 | Casos pontuais (Campinas, RJ capital e Nova Iguaçu) | Contidos Notificações isoladas com controle local. |
| Nota: A Anvisa considera “surto” a ocorrência de 1 único caso em serviço de saúde. Casos incluem infecções e colonizações. |
Além desses, há relatos de casos pontuais notificados em Campinas (SP), Rio de Janeiro (capital e Nova Iguaçu) e outras localidades em 2023.
O que esses dados indicam para a prevenção hospitalar?
- A recorrência de casos mostra que o fungo Candida auris se dissemina silenciosamente, e que hospitais precisam de monitoramento contínuo e limpeza especializada.
- Em locais como Belo Horizonte (BH), o termo “superfungo Candida auris BH” ganhou relevância: o surto local reforça a necessidade de planos de controle específicos adaptados à realidade regional.
- Os dados confirmam que casos de colonização são a maioria, o que exige atenção mesmo naqueles pacientes que não apresentam sintomas — afinal, podem ser vetores de contaminação ambiental.
- Hospitais que responderam adequadamente aos surtos usaram protocolos rigorosos de desinfecção, isolamento e testagem laboratorial (com tecnologia como MALDI-TOF) para identificação correta do fungo.
Quais os sintomas da Candida auris?
Apesar de seu potencial agressivo, a Candida auris pode se manifestar de formas sutis no organismo — ou até permanecer silenciosa como colonizadora da pele e muco. Compreender seus sintomas e padrões é essencial para diagnóstico precoce e controle no ambiente hospitalar.
Infecção invasiva vs colonização
- Colonização: nessa condição, o fungo Candida auris está presente na pele ou mucosas sem causar doença aparente. Pode persistir por semanas ou meses e servir como fonte de disseminação ambiental.
- Infecção invasiva: ocorre quando o microrganismo invade o sangue, tecidos internos ou órgãos, especialmente em pacientes imunossuprimidos ou com dispositivos invasivos (como cateteres, ventiladores, sondas).
Sinais e sintomas mais comuns
As manifestações clínicas dependem do local da infecção e do estado clínico do paciente. Alguns sintomas frequentes:
- Febre persistente que não responde a antibióticos
- Calafrios intensos
- Bacteremia ou fungemia (fungo na corrente sanguínea), causando queda na pressão, sepse
- Infecções em locais específicos: trato urinário, feridas cirúrgicas infectadas, pneumonia associada a ventilação mecânica
- Em alguns pacientes, colonização na pele — em regiões como axilas, virilha e superfícies de ventiladores ou roupas de cama
Candida auris na pele e imagens
- A presença de Candida auris pode ocorrer na pele de pacientes colonizados, especialmente em áreas úmidas (axilas, virilha).
- Em muitos casos, não há sintomas visíveis quando está na pele — por isso é facilmente transferido para superfícies hospitalares.
- Para ilustrar, uso de imagens de microscopia eletrônica ou cultura em meio seletivo pode ajudar a mostrar a morfologia característica do fungo.
Diagnóstico laboratorial e desafios
- Métodos rotineiros de laboratório geralmente não distinguem Candida auris de outras espécies de Candida, levando a identificação incorreta.
- Técnicas modernas como MALDI-TOF MS, PCR ou sequenciamento genético são mais confiáveis para a detecção do superfungo.
- A demora no diagnóstico pode retardar a implementação de medidas de contenção ambiental e terapêuticas.
Identificar corretamente o superfungo Candida auris é o primeiro passo para interromper sua cadeia de transmissão.
Mais do que reconhecer sintomas clínicos, é fundamental compreender que ele pode permanecer invisível, colonizando pele, superfícies e equipamentos hospitalares.

Por que o superfungo Candida auris preocupa tanto?
O superfungo Candida auris tem sido motivo de crescente preocupação mundial por parte de órgãos de saúde, como a Organização Mundial da Saúde (OMS) e o Centro de Controle e Prevenção de Doenças (CDC).
Desde sua descoberta, em 2009, o fungo já foi identificado em mais de 40 países, incluindo o Brasil, e é considerado um dos patógenos hospitalares mais difíceis de controlar.
Mas afinal, por que ele representa um risco tão grande à saúde pública e à segurança hospitalar? Abaixo, estão os três principais motivos que tornam o Candida auris um verdadeiro desafio para a medicina moderna e para as equipes de limpeza profissional.
+SAIBA MAIS: Hotelaria Hospitalar: O Que É, Como Funciona e Por Que é Essencial para Paciente e Hospitais?
Resistência a múltiplos antifúngicos
O fungo Candida auris é altamente multirresistente — ou seja, ele não responde a muitos dos antifúngicos normalmente utilizados para tratar infecções do gênero Candida, como os das classes azóis, equinocandinas e polienos.
Em algumas cepas, a resistência é total, impossibilitando qualquer tratamento farmacológico eficaz.
Essa característica coloca o Candida auris na lista da OMS de “patógenos fúngicos prioritários”, destacando-o como uma ameaça crítica à saúde global.
Na prática, isso significa que surtos hospitalares podem ocorrer mesmo em locais com alto padrão de assistência, caso o controle ambiental e o uso de desinfetantes adequados não sejam rigorosos.
Dificuldade de identificação laboratorial
Outra razão pela qual o superfungo Candida auris preocupa tanto é sua semelhança com outras espécies de Candida, o que leva a erros de diagnóstico em laboratórios que utilizam métodos convencionais.
Durante anos, o auris candida foi erroneamente classificado como Candida haemulonii ou Candida parapsilosis, o que atrasava o tratamento e o isolamento dos pacientes infectados.
Hoje, a identificação precisa depende de tecnologias avançadas, como:
- MALDI-TOF MS (espectrometria de massa),
- Testes de biologia molecular (PCR),
- e sequenciamento genético completo.
A Anvisa recomenda que todos os laboratórios clínicos estejam preparados para reconhecer o fungo e notificar imediatamente à Comissão de Controle de Infecção Hospitalar (CCIH) e às secretarias estaduais de vigilância.
Capacidade de causar surtos hospitalares
Talvez o fator mais alarmante da Candida auris seja sua facilidade de disseminação em ambientes de saúde.
O fungo sobrevive por dias ou até semanas em superfícies inanimadas — como camas, cortinas, monitores, ventiladores mecânicos e maçanetas — resistindo inclusive a muitos produtos de limpeza comuns.
Quando o controle ambiental não é adequado, o resultado é a rápida propagação do superfungo hospitalar, provocando surtos em UTIs e centros cirúrgicos.
Foi o que ocorreu em diversos hospitais brasileiros, como o Hospital João XXIII em Belo Horizonte (BH) e o Hospital do Servidor Público Estadual (HSPE) em São Paulo, entre 2024 e 2025.
O impacto para a limpeza hospitalar e a segurança do paciente
A disseminação do superfungo Candida auris evidencia que a limpeza hospitalar não é apenas estética — é uma barreira de biossegurança.
O uso de desinfetantes profissionais de alta performance, como os da linha Optigerm, torna-se indispensável para eliminar o fungo de superfícies e reduzir o risco de novos surtos.
Produtos como o Optigerm Pronto-Uso (com ação em 1 minuto) e o Optigerm Oxikill (eficaz em 10 minutos, mesmo com matéria orgânica) são exemplos de tecnologias que unem limpeza e desinfecção em uma única etapa, garantindo eficácia comprovada contra o superfungo Candida auris.
Como previnir e combater a Candida auris em ambientes hospitalares?
A prevenção contra o superfungo Candida auris exige medidas específicas, consistentes e contínuas. Por sua capacidade de resistir a agentes químicos e permanecer ativo em superfícies, esse fungo hospitalar demanda protocolos de higienização profissional altamente rigorosos, especialmente em UTIs, salas cirúrgicas e áreas críticas.
De acordo com orientações da Anvisa, CDC e OMS, a prevenção se baseia em três pilares fundamentais: identificação precoce, isolamento de casos e desinfecção ambiental adequada.
Identificação precoce e isolamento
O primeiro passo para conter a disseminação do auris candida é o reconhecimento rápido de casos suspeitos. Laboratórios devem estar capacitados para diferenciar Candida auris de outras espécies do mesmo gênero, utilizando tecnologias como MALDI-TOF ou PCR.
Assim que um caso é identificado — mesmo em situações de colonização da pele —, o paciente deve ser isolado de contato, preferencialmente em quarto individual ou coorte com outros pacientes colonizados.
A equipe de saúde deve adotar precauções rigorosas, incluindo:
- Uso de luvas e avental descartável a cada atendimento;
- Desinfecção completa de equipamentos após o uso;
- Higienização das mãos antes e depois de qualquer contato.
Essas práticas reduzem o risco de transmissão cruzada e interrompem o ciclo de contaminação.
+LEIA TAMBÉM: PHMB e Biguanida: Como funcionam na limpeza e na saúde?
Limpeza e desinfecção de superfícies
A limpeza ambiental é a etapa mais crítica para conter o superfungo Candida auris. O fungo pode permanecer viável por dias ou até semanas em superfícies secas, o que o torna um desafio mesmo para protocolos de limpeza bem estruturados.
Produtos recomendados:
Os estudos laboratoriais indicam que a Candida auris é sensível a desinfetantes que contenham:
- Biguanida (PHMB – Polihexametileno Biguanida);
- Quaternário de amônio de 5ª geração;
- Peróxido de hidrogênio.
Esses princípios ativos estão presentes nos desinfetantes hospitalares da linha Optigerm, desenvolvidos pela Oleak e distribuídos pela Higiclear:
- Optigerm Pronto-Uso: elimina Candida auris em 1 minuto de contato, com efeito residual de até 30 dias.
- Optigerm Oxikill: elimina o superfungo em 10 minutos, mesmo na presença de matéria orgânica, com efeito residual de 7 dias.
Ambos atuam em superfícies fixas e artigos não críticos, substituindo com eficiência produtos convencionais, como álcool 70%.
Rotina de higienização e frequência
Para ser eficaz, a limpeza deve seguir um protocolo padronizado, dividido por áreas:
- UTIs e unidades críticas: desinfecção a cada troca de plantão e imediatamente após qualquer procedimento.
- Superfícies de alto toque: maçanetas, grades, monitores e bombas de infusão devem ser higienizados várias vezes ao dia.
- Pisos e superfícies horizontais: limpeza úmida diária com produtos registrados na Anvisa para uso hospitalar.
A documentação das rotinas (checklists e planilhas de controle) é fundamental para rastreabilidade e auditorias internas.
Treinamento e cultura de prevenção
O sucesso no combate ao superfungo hospitalar Candida auris depende também do fator humano.
Equipes de limpeza e enfermagem devem receber treinamentos periódicos sobre:
- Identificação visual e microbiológica do fungo;
- Correta utilização dos EPIs;
- Diluição e tempo de contato dos desinfetantes;
- E gestão de resíduos potencialmente contaminados.
A Higiclear oferece programas de capacitação técnica em limpeza hospitalar, orientando sobre os melhores protocolos de desinfecção e uso racional de produtos certificados pela Anvisa.
Prevenir a disseminação da Candida auris não é apenas uma questão de protocolo, mas de segurança do paciente e responsabilidade institucional.
Hospitais que aplicam metodologias de limpeza baseadas em evidências — com produtos eficazes, equipes treinadas e vigilância constante — reduzem drasticamente o risco de surtos e protegem suas equipes e pacientes.
No próximo capítulo, exploraremos os produtos comprovadamente eficazes contra a Candida auris, com foco técnico na linha Optigerm e nas suas vantagens operacionais para ambientes hospitalares.


Quais produtos combatem a Candida auris?
O combate ao superfungo hospitalar Candida auris exige o uso de desinfetantes com eficácia comprovada e registro ativo na Anvisa, capazes de eliminar microrganismos resistentes em curtos tempos de contato.
Produtos comuns, como álcool 70% e compostos clorados genéricos, não são suficientes para eliminar o fungo de superfícies críticas.
Por isso, instituições de saúde vêm adotando soluções profissionais de alta performance, formuladas com princípios ativos de amplo espectro, capazes de agir sobre o auris candida e outros patógenos hospitalares multirresistentes.
Linha Optigerm – Desinfecção segura e comprovada
A linha Optigerm, desenvolvida pela Oleak e distribuída pela Higiclear, reúne produtos de desinfecção profissional com eficácia comprovada contra a Candida auris.
Essa linha combina quaternário de amônio de 5ª geração, biguanida (PHMB) e, em algumas formulações, peróxido de hidrogênio, criando uma ação sinérgica que limpa e desinfeta ao mesmo tempo.

Optigerm Pronto-Uso
- Ação comprovada contra a Candida auris em 1 minuto de contato;
- Contém biguanida + quaternário de amônio 5ª geração;
- Limpa e desinfeta simultaneamente, reduzindo etapas operacionais;
- Efeito residual de até 30 dias, garantindo proteção prolongada das superfícies;
- Seguro para uso em monitores, equipamentos médicos e superfícies sensíveis;
- Substitui o álcool 70% com melhor custo-benefício e menor volatilidade.
- Ideal para: hospitais, clínicas, laboratórios, consultórios odontológicos e centros cirúrgicos.

Optigerm Oxikill
- Elimina a Candida auris em 10 minutos de contato, mesmo na presença de matéria orgânica;
- Combina peróxido de hidrogênio + quaternário de amônio + biguanida (PHMB);
- Atua como limpador, alvejante e desinfetante em uma única operação;
- Efeito residual de até 7 dias;
- Diluição simples: 1:100, com rendimento otimizado;
- Alta compatibilidade com superfícies hospitalares, pisos vinílicos e inoxidáveis.
- Ideal para: áreas críticas, UTIs, enfermarias, laboratórios e salas cirúrgicas.
Tabela comparativa dos produtos Optigerm:
| Produto | Tempo de contato | Ativos principais | Tipo de uso | Efeito residual |
|---|---|---|---|---|
| Optigerm Pronto-Uso | 1 minuto | Biguanida (PHMB) + Quaternário 5ª geração | Superfícies fixas e artigos não críticos | Até 30 dias |
| Optigerm Oxikill | 10 minutos | Peróxido de Hidrogênio + Quaternário + Biguanida | Superfícies fixas, pisos e artigos não críticos | Até 7 dias |
Benefícios operacionais para o setor hospitalar
- Redução do tempo de limpeza: ação combinada de limpeza e desinfecção em uma única aplicação.
- Eficiência comprovada contra fungos e bactérias multirresistentes, incluindo Candida auris, Acinetobacter baumannii e Staphylococcus aureus.
- Segurança química: pH neutro, baixo odor e ausência de compostos clorados.
- Maior rendimento operacional, com menor desperdício de produto e menor necessidade de retrabalho.
O controle da Candida auris vai muito além do uso de produtos genéricos. Ele exige soluções com laudos técnicos, registro Anvisa e tecnologia comprovada de desinfecção.
+LEIA MAIS: O uso do spray cleaning na limpeza hospitalar: Um estudo de caso com Optigerm Oxikill.
Com a linha Optigerm, hospitais e clínicas obtêm uma camada de proteção adicional — essencial para prevenir surtos, preservar a saúde dos pacientes e garantir conformidade com as normas sanitárias vigentes.
Opinião do Especialista:
“A Candida auris é um desafio real, mas com os desinfetantes da linha Optigerm e os programas de capacitação técnica oferecidos pela Higiclear, o controle desse superfungo torna-se muito mais eficaz, seguro e sustentável dentro dos ambientes hospitalares.” – Richard Rocamora, Gerente Comercial da Higiclear
FAQ – Perguntas Frequentes sobre Candida auris
1. O que é a Candida auris?
A Candida auris é um superfungo hospitalar identificado pela primeira vez em 2009, no Japão. Ele causa infecções graves e é conhecido por sua alta resistência a medicamentos antifúngicos e dificuldade de eliminação em superfícies hospitalares.
2. Como ocorre a transmissão da Candida auris?
O fungo Candida auris se transmite principalmente por contato direto com pacientes colonizados ou contaminados e por superfícies e equipamentos hospitalares. Ele pode permanecer ativo por dias, tornando indispensável a desinfecção rigorosa do ambiente.
3. Quais são os sintomas da infecção por Candida auris?
Os sintomas incluem febre persistente, calafrios, infecções na corrente sanguínea, no trato urinário e em feridas cirúrgicas. Em alguns casos, a Candida auris na pele pode ocorrer sem sintomas aparentes, funcionando como foco de disseminação.
4. Onde a Candida auris é mais encontrada?
Ela é mais frequente em hospitais e UTIs, principalmente em superfícies de alto toque (como grades, camas, ventiladores e monitores). Casos no Brasil já foram confirmados em Bahia, Pernambuco, Minas Gerais e São Paulo (BH e HSPE), segundo a Anvisa.
5. Quais produtos eliminam a Candida auris de superfícies?
Somente desinfetantes hospitalares de alta performance têm eficácia comprovada. A linha Optigerm, da Oleak, distribuída pela Higiclear, elimina a Candida auris em até 1 minuto de contato, graças à combinação de biguanida (PHMB), quaternário de amônio de 5ª geração e peróxido de hidrogênio.
Higiclear: sua parceira na promoção da saúde em ambientes hospitalares.
O surgimento do superfungo Candida auris é um lembrete de que a higienização profissional é uma ferramenta essencial de biossegurança. Mais do que uma rotina operacional, ela é um componente estratégico na prevenção de surtos, na segurança do paciente e na credibilidade das instituições de saúde.
Na Higiclear, acreditamos que combater microrganismos resistentes exige tecnologia, capacitação e compromisso. Por isso, trabalhamos ao lado de nossos parceiros e clientes oferecendo produtos certificados, treinamento técnico e consultoria especializada para implementação de protocolos de limpeza seguros e eficazes.
A linha Optigerm, desenvolvida pela Oleak e distribuída pela Higiclear, é o resultado dessa união entre ciência e prática profissional. Com eficácia comprovada contra o superfungo Candida auris, os produtos Optigerm Pronto-Uso e Optigerm Oxikill garantem proteção prolongada, desinfecção rápida e segurança ocupacional, atendendo às exigências da Anvisa, CDC e OMS.
Deseja elevar o padrão de higiene e controle microbiológico em seu ambiente de saúde? Fale com os especialistas da Higiclear e descubra como nossos desinfetantes hospitalares e treinamentos técnicos podem transformar a rotina de limpeza da sua instituição, com resultados mensuráveis, economia e segurança.
Ou, se preferir, acesse nossos materiais gratuitos e aprimore sua gestão de higiene profissional com base técnica:
📘 Conheça a Cronograma de Limpeza da Higiclear
📊 Calculadora de Diluição de Produtos de Limpeza
🎨 Saiba tudo sobre a Limpeza por Cores
Esclarecer dúvidas, orientar e oferecer sempre o melhor em técnicas e produtos de limpeza profissional é a nossa missão na Higiclear. Conte sempre com a gente para fazer escolhas que atendam às necessidades de sua empresa.
Se você gostou das informações sobre Candida Auris, compartilhe com mais pessoas, nos acompanhe nas redes sociais sobre limpeza, nos siga nas plataformas de áudio de limpeza profissional e acompanhe nosso site para não perder dicas de limpeza profissional e conhecer nossas soluções de limpeza profissional.
Até a próxima semana!
Visto primeiro em Higiclear
Referências:
- Comunicado de Risco nº 01/2017 – Infecções por Candida auris em serviços de saúde – ANVISA
- Nota Técnica GVIMS/GGTES nº 01/2023 – Atualização sobre Candida auris no Brasil
- Candida auris: Clinical Overview
- Infection Control Guidance: Candida auris
- WHO fungal priority pathogens list to guide research, development and public health action – OMS
- Identificação de caso de Candida auris no Brasil – Biblioteca Virtual em Saúde